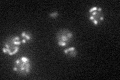

View description
Mitochondrial external NADH dehydrogenase, a type II NAD(P)H:quinone oxidoreductase that catalyzes the oxidation of cytosolic NADH; Nde1p and Nde2p provide cytosolic NADH to the mitochondrial respiratory chain
Localization:
Intensity:
Fold change:
Significance:
-
C’ GFP library in SD

mitochondria82.23 -
N' NOP1pr-GFP in SD

mitochondria185.125 -
N' TEF2pr-mCherry in SD

missing0 -
N' NATIVEpr-GFP in SD

mitochondria65.6268 -
N' TEF2pr-VC and Cyto-VN in SD

#N/A0 -
C’ GFP library in SD+DTT

mitochondria66.820.81No -
C’ GFP library in SD+H2O2

mitochondria81.260.98No -
C’ GFP library in Starvation Media
mitochondria41.180.5Yes -
C’ GFP library on the background of Pup2-DaMP

N/A -
C’ GFP library on the background of CCT mutant

N/A0N/AYes
